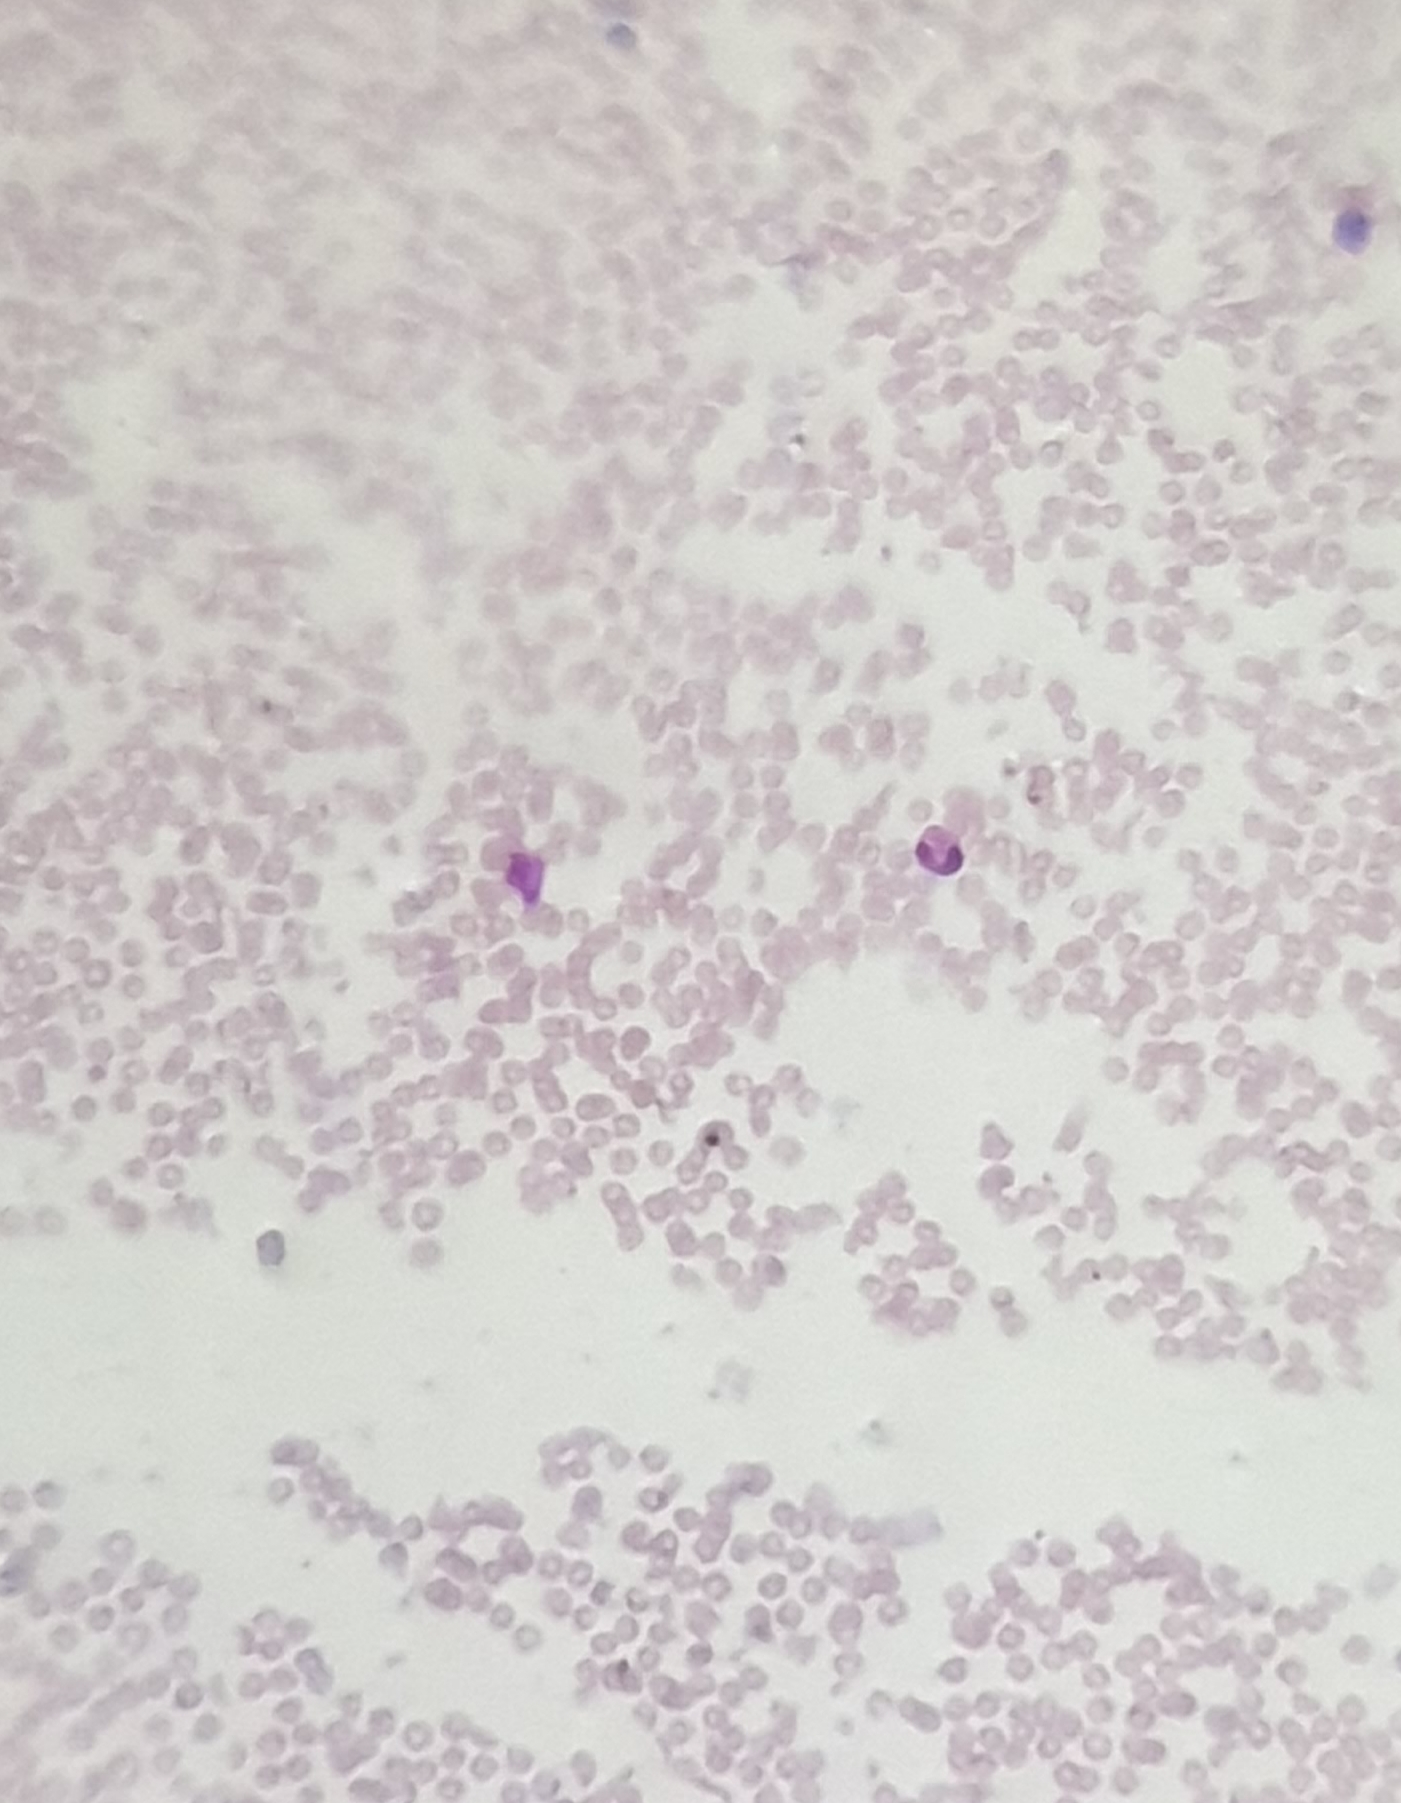
20191014_103032.jpg

Activity

Unknown

Microorganisms

Fungi & Lichen

Plants

Insects

Animals

Non Living

Information

Workshops

Lesson Plans
Mediashowing 12 of 75

Photo posted on Jan 19, 2026
image

Photo posted on Jan 19, 2026
image

Photo posted on Jan 19, 2026
image

Photo posted on Dec 23, 2025
image

Photo posted on Dec 23, 2025
image

Photo posted on Dec 23, 2025
image
Photo posted on Dec 23, 2025
image

Photo posted on Dec 23, 2025
image

Photo posted on Dec 23, 2025
image

Photo posted on Dec 23, 2025
image

Photo posted on Dec 23, 2025
image

Photo posted on Dec 23, 2025
image
More Posts from Gagandeep Kaurshowing 20 of 74
Similar Foldscopers
I am a faculty at Stanford and run the Prakash Lab at Department of Bioengineering at Stanford University. Foldscope community is at the heart of our Frugal Science movement - and I can not tell you how proud I am of this community and grassroots movement. Find our work here: http://prakashlab.stanford.edu
No post images available.
No biography available.
No post images available.
No biography available.
No post images available.
Science Teacher, Foldscope explorer, music practitioner
No post images available.
No biography available.
No post images available.
No biography available.
No post images available.
No biography available.
No post images available.
I work in the field of Clinical Research and volunteer at Lulwanda Children's Home and School in Mbale, Uganda.
No post images available.
Working as an Assistant Professor of Zoology, Nizam College, A constituent college of Osmania University, Hyderabad, Telangana, India.
Area of Interest is Freshwater Protozoan Ecology, Ecotoxicology and Environmental Safety.
No post images available.
No biography available.
No post images available.

 Joined Nov 01, 2018
Joined Nov 01, 2018
 0 Applause
0 Applause 0 Comments
0 Comments


























